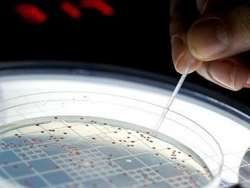
Свехчувствительный датчик

Georgia Tech создала точный датчик, который мог бы изменить отношение к устройствам на основе такого рода сенсоров. Датчик из нанопроволоки преобразует давление в свет и может привести к созданию сверхчувствительных устройств с сенсорным управлением.
Georgia Tech создала точный датчик, который мог бы изменить отношение к устройствам на основе такого рода сенсоров. Датчик из нанопроволоки преобразует давление в свет и может привести к созданию сверхчувствительных устройств с сенсорным управлением.
Нанопровода выращивают на пленке из нитрида галлия, при этом свет исходит от «корней», где каждый из проводов соприкасается с указанным субстратом. Когда какой-то проводов подвергается нагрузкам (например, через давление, оказываемое стилусом или отпечатками пальцев), возникает пьезоэлектрический заряд — чем сильнее нагрузка, тем сильнее заряд и тем ярче свечение.
Когда пользователь нажимает на новый датчик, его сетка оксида цинка из нанопроводов излучает свет, который захватывается волоконной оптикой с очень высокой чувствительностью в 6300 dpi. По утверждениям ученых, массивы пьезо-фотоэлектронных светодиодов реагируют на давление за пару миллисекунд,
Сочетание высокого разрешения со скоростью света может привести к созданию сверх чувствительных сенсоров, которые не доступны в настоящее время.
В то время как вычислительные интерфейсы являются первыми кандидатами на использование новой технологии, Georgia Tech также видит потенциал использования сверхчувствительных датчиков давления в сканерах отпечатков пальцев и даже в устройствах, имитирующих контакт с кожей при создании биороботов.



